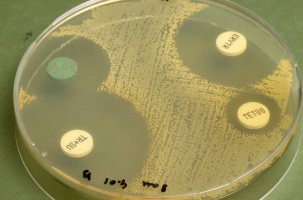

Projecten
In 2013 startte 1Health4Food met twee onderzoeksprojecten die inspelen op urgente en actuele vraagstukken:
ESBL-attributie (op zoek naar de bronnen van antibioticumresistentie bij de mens) en Diagnostiekontwikkeling en –toepassingen. Inmiddels heeft 1Health4Food een uitgebreide onderzoeksportefeuille opgebouwd.